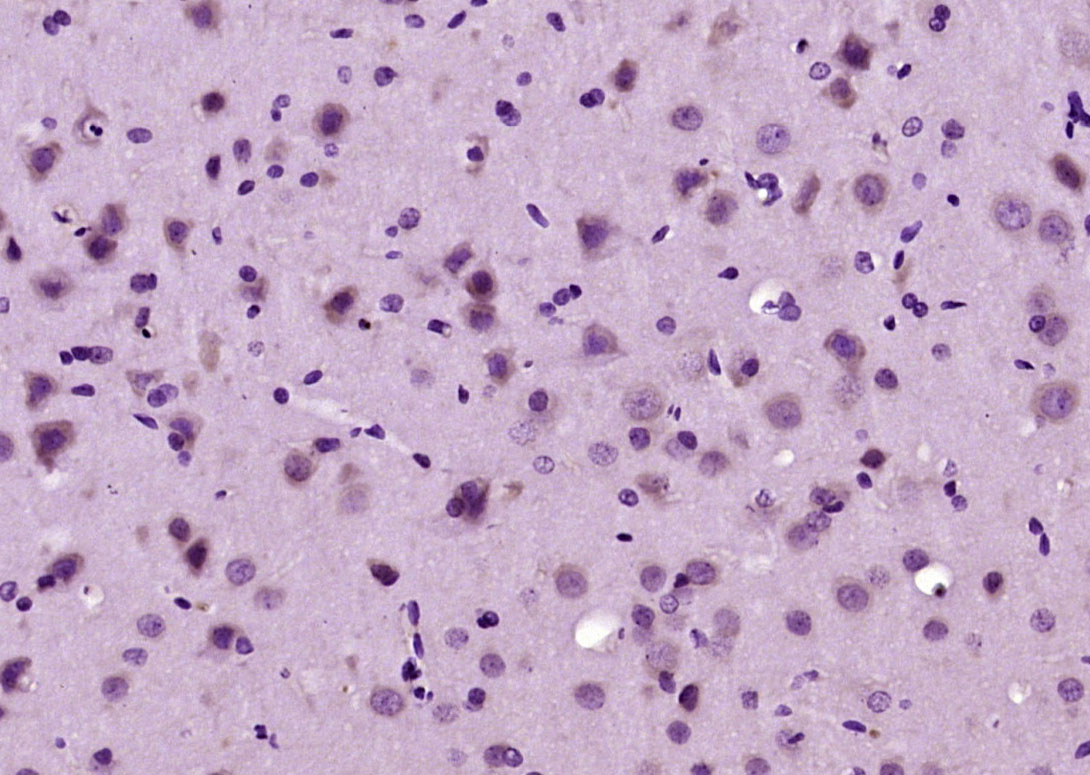
phospho-PLCG1 (Tyr783) Rabbit

Tissue/cell: Rat rectal cancer; 4% Paraformaldehyde-fixed and paraffin-embedded;
Antigen retrieval: citrate buffer ( 0.01M, pH 6.0 ), Boiling bathing for 15min; Block endogenous peroxidase by 3% Hydrogen peroxide for 30min; Blocking buffer (normal goat serum,C-0005) at 37℃ for 20 min;
Incubation: Anti- PLCγ1 Polyclonal Antibody, Unconjugated(bs-3343R) 1:200, overnight at 4°C, followed by conjugation to the secondary antibody(SP-0023) and DAB(C-0010) staining
相关产品推荐更多 >
万千商家帮你免费找货
0 人在求购买到急需产品
- 详细信息
- 文献和实验
- 技术资料
- 应用范围:
产品信息以Bioss网站为准
- 规格:
50ul/100ul/200ul
| 规格: | 50ul | 产品价格: | ¥1180.0 |
|---|---|---|---|
| 规格: | 100ul | 产品价格: | ¥1980.0 |
| 规格: | 200ul | 产品价格: | ¥2800.0 |
| 产品编号 | bs-3343R |
| 英文名称 | phospho-PLCG1 (Tyr783) Rabbit pAb |
| 中文名称 | 磷酸化磷酯酶Cγ1抗体 |
| 英文别名 | PLCG1_HUMAN; PLC gamma 1; 1 phosphatidyl D myo inositol 4 5 bisphosphate; 1 phosphatidylinositol 4 5 bisphosphate; 1 phosphatidylinositol 4 5 bisphosphate phosphodiesterase gamma 1; 1-phosphatidylinositol-4, 5-bisphosphate phosphodiesterase gamma-1; inositoltrisphosphohydrolase; monophosphatidylinositol phosphodiesterase; NCKAP3; phosphatidylinositol phospholipase C; phosphodiesterase gamma 1; phosphoinositidase C; phosphoinositide phospholipase C; phosphoinositide phospholipase C-gamma-1; phospholipase C 148; phospholipase C 148; phospholipase C gamma 1(formerly subtype 148); phospholipase C gamma 1; phospholipase C gamma 1; phospholipase C-148; phospholipase C-gamma-1; phospholipase C-II; PLC 1; PLC 148; PLC II; PLC-148; PLC-gamma-1; PLC-II; PLC1; PLC148; PLCG 1; PLCG-1; PLCgamma1; PLCII; triphosphoinositide phosphodiesterase. |
| 产品应用 | IHC-P=1:100-500, IHC-F=1:100-500, IF=1:100-500 Not yet tested in other applications. |
| 交叉反应 | Rat (Human, Mouse, Chicken, Dog, Pig, Horse) |
| 抗体来源 | Rabbit |
| 免疫原 | KLH conjugated Synthesised phosphopeptide derived from human PLC gamma 1 around the phosphorylation site of Tyr783 |
| 亚型 | IgG |
| 性状 | Liquid |
| 纯化方法 | affinity purified by Protein A |
| 克隆类型 | Polyclonal |
| 理论分子量 | 148 kDa |
| 浓度 | 1mg/ml |
| 储存液 | 0.01M TBS (pH7.4) with 1% BSA, 0.02% Proclin300 and 50% Glycerol. |
| 亚基 | Interacts with AGAP2 via its SH3 domain. Interacts (via SH2 domain) with RET. Interacts with FLT1 (tyrosine-phosphorylated). Interacts (via SH2 domain) with FGFR1, FGFR2, FGFR3 and FGFR4 (phosphorylated). Interacts with LAT (phosphorylated) upon TCR activation. Interacts (via SH3 domain) with the Pro-rich domain of TNK1. Associates with BLNK, VAV1, GRB2 and NCK1 in a B-cell antigen receptor-dependent fashion. Interacts with CBLB in activated T-cells; which inhibits phosphorylation. Interacts with SHB. Interacts (via SH3 domain) with the Arg/Gly-rich-flanked Pro-rich domains of KHDRBS1/SAM68. This interaction is selectively regulated by arginine methylation of KHDRBS1/SAM68. Interacts with INPP5D/SHIP1, THEMIS and CLNK. Interacts with AXL, FLT4 and KIT. Interacts with RALGPS1. Interacts (via SH3 domain) with HEV ORF3 protein. Interacts (via the SH2 domains) with VIL1 (phosphorylated at C-terminus tyrosine phosphorylation sites). Interacts (via SH2 domain) with PDGFRA and PDGFRB (tyrosine phosphorylated). Interacts with PIP5K1C (By similarity). Interacts with NTRK1 and NTRK2 (phosphorylated upon ligand-binding). Interacts with SYK; activates PLCG1. Interacts with GRB2, LAT and THEMIS upon TCR activation in thymocytes. Interacts with TESPA1; the association is increased with prolonged stimulation of the TCR and may facilitate the assembly of the LAT signalosome. |
| 亚细胞定位 | Cell projection, lamellipodium. Cell projection, ruffle. Note=Rapidly redistributed to ruffles and lamellipodia structures in response to epidermal growth factor (EGF) treatment. |
| 翻译后修饰 | Tyrosine phosphorylated in response to signaling via activated FLT3, KIT and PDGFRA (By similarity). Tyrosine phosphorylated by activated FGFR1, FGFR2, FGFR3 and FGFR4. Tyrosine phosphorylated by activated FLT1 and KDR. Tyrosine phosphorylated by activated PDGFRB. The receptor-mediated activation of PLCG1 involves its phosphorylation by tyrosine kinases, in response to ligation of a variety of growth factor receptors and immune system receptors. For instance, SYK phosphorylates and activates PLCG1 in response to ligation of the B-cell receptor. May be dephosphorylated by PTPRJ. Phosphorylated by ITK and TXK on Tyr-783 upon TCR activation in T-cells.
Ubiquitinated by CBLB in activated T-cells. |
| 相似性 | Contains 1 C2 domain. Contains 1 EF-hand domain. Contains 2 PH domains. Contains 1 PI-PLC X-box domain. Contains 1 PI-PLC Y-box domain. Contains 2 SH2 domains. Contains 1 SH3 domain. |
| 功能 | Mediates the production of the second messenger molecules diacylglycerol (DAG) and inositol 1,4,5-trisphosphate (IP3). Plays an important role in the regulation of intracellular signaling cascades. Becomes activated in response to ligand-mediated activation of receptor-type tyrosine kinases, such as PDGFRA, PDGFRB, FGFR1, FGFR2, FGFR3 and FGFR4. Plays a role in actin reorganization and cell migration. |
| 保存条件 | Shipped at 4℃. Store at -20℃ for one year. Avoid repeated freeze/thaw cycles. |
| 注意事项 | This product as supplied is intended for research use only, not for use in human, therapeutic or diagnostic applications. |
| 背景资料 | The protein encoded by this gene catalyzes the formation of inositol 1,4,5-trisphosphate and diacylglycerol from phosphatidylinositol 4,5-bisphosphate. This reaction uses calcium as a cofactor and plays an important role in the intracellular transduction of receptor-mediated tyrosine kinase activators. For example, when activated by SRC, the encoded protein causes the Ras guanine nucleotide exchange factor RasGRP1 to translocate to the Golgi, where it activates Ras. Also, this protein has been shown to be a major substrate for heparin-binding growth factor 1 (acidic fibroblast growth factor)-activated tyrosine kinase. Two transcript variants encoding different isoforms have been found for this gene. [provided by RefSeq, Jul 2008]. |
| 应用 | 推荐稀释比例 |
| {IHC-P} | {1:100-500} |
| {IHC-F} | {1:100-500} |
| {IF} | {1:100-500} |


Tissue/cell: Rat lung tissue; 4% Paraformaldehyde-fixed and paraffin-embedded;
Antigen retrieval: citrate buffer ( 0.01M, pH 6.0 ), Boiling bathing for 15min; Block endogenous peroxidase by 3% Hydrogen peroxide for 30min; Blocking buffer (normal goat serum,C-0005) at 37℃ for 20 min;
Incubation: Anti- PLCγ1 Polyclonal Antibody, Unconjugated(bs-3343R) 1:200, overnight at 4°C, followed by conjugation to the secondary antibody(SP-0023) and DAB(C-0010) staining
Antigen retrieval: citrate buffer ( 0.01M, pH 6.0 ), Boiling bathing for 15min; Block endogenous peroxidase by 3% Hydrogen peroxide for 30min; Blocking buffer (normal goat serum,C-0005) at 37℃ for 20 min;
Incubation: Anti- PLCγ1 Polyclonal Antibody, Unconjugated(bs-3343R) 1:200, overnight at 4°C, followed by conjugation to the secondary antibody(SP-0023) and DAB(C-0010) staining
Paraformaldehyde-fixed, paraffin embedded (rat brain); Antigen retrieval by boiling in sodium citrate buffer (pH6.0) for 15min; Block endogenous peroxidase by 3% hydrogen peroxide for 20 minutes; Blocking buffer (normal goat serum) at 37°C for 30min; Antibody incubation with (Phospho-PLC gamma 1 (Tyr783)) Polyclonal Antibody, Unconjugated (bs-3343R) at 1:200 overnight at 4°C, followed by operating according to SP Kit(Rabbit) (sp-0023) instructionsand DAB staining.
风险提示:丁香通仅作为第三方平台,为商家信息发布提供平台空间。用户咨询产品时请注意保护个人信息及财产安全,合理判断,谨慎选购商品,商家和用户对交易行为负责。对于医疗器械类产品,请先查证核实企业经营资质和医疗器械产品注册证情况。
文献和实验该产品被引用文献
[IF={{ 7.5 }}] {E. Diaz-Flores, et al."PLC-γ and PI3K Link Cytokines to ERK Activation in Hematopoietic Cells with Normal and Oncogenic Kras." Sci. Signal. 6, ra105 (2013).} {Other} {="Mouse"}
技术资料暂无技术资料 索取技术资料
文献支持
phospho-PLCG1 (Tyr783) Rabbit pAb(bs-3343R)-50ul/100ul/200ul
¥1180 - 2800








